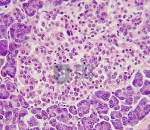
Artery, Vein &amp; Nerve (400x)

Microscope Slides Manufacturer, Suppliers and Exporter in India
Educational Equipments is leading Microscope Slides Manufacturer,and supplier and Exporter in Ambala India, Algeria (Algiers), Angola (Luanda), Argentina (Buenos Aires), Armenia (Yerevan), Australia(Canberra), Austria (Vienna), Bahrain (Manama), Bangladesh (Dhaka), Bhutan (Thimphu), Bolivia (Sucre), Botswana (Gaborone), Brazil (Brasília), Brunei (Bandar Seri Begawan), Montenegro (Podgorica), Morocco (Rabat), Mozambique (Maputo), Myanmar (Naypyidaw), Namibia (Windhoek), Nepal (Kathmandu), New Zealand (Wellington), Nigeria (Abuja), Oman (Muscat), Palestine (Ramallah), Panama (Panama City), Papua New Guinea (Port Moresby), Paraguay (Asunción), Peru (Lima), Philippines (Manila)¸ Portugal (Lisbon), Qatar (Doha), Rwanda (Kigali), Saudi Arabia (Riyadh), Senegal (Dakar), Serbia (Belgrade), Sierra Leone (Freetown), Slovakia (Bratislava), South Africa (Cape Town) (Pretoria) (Bloemfontein), South Sudan (Juba), Spain (Madrid), Sri Lanka (Sri Jayawardenepura Kotte) (Colombo), Sudan (Khartoum), Syria (Damascus), Tanzania (Dodoma), Thailand (Bangkok), Togo (Lomé), Tonga (Nuku'alofa), Trinidad and Tobago (Port of Spain), Tunisia (Tunis), Turkey (Ankara), Turkmenistan (Ashgabat), Uganda (Kampala), United Arab Emirates (Abu Dhabi), United Kingdom (London), United States (Washington, D.C.)
Educational Lab Equipment is a globally trusted Microscope Slides Manufacturer, Exporter, and Supplier in India, specializing in precision-engineered laboratory glass consumables for chemical research laboratories, university chemistry departments, and pharmaceutical quality control laboratories. Operating from an advanced glass processing facility in India, the company demonstrates strong Borosilicate 3.3 glass manufacturing capability designed to meet stringent international laboratory standards. Production systems comply with ISO 9001 quality management ensuring controlled manufacturing consistency and ISO 14001 environmental management validating sustainable glass processing operations. Educational Lab Equipment develops microscope slides engineered for thermal resistance, chemical durability, and low coefficient of expansion properties aligned with ASTM E438 Type 1 Class A glass quality benchmarks and USP laboratory testing standards. The company supports institutional procurement and regulated pharmaceutical environments requiring dependable glass slide precision and material purity for analytical and diagnostic laboratory applications.
Educational Lab Equipment manufactures Plain Microscope Slides using Borosilicate 3.3 glass verified under ASTM E438 Type 1 Class A chemical durability standards ensuring superior heat and reagent resistance. Frosted End Microscope Slides comply with DIN ISO 8037 optical clarity and surface finishing standards ensuring clear specimen labeling and contamination-free sample handling. Ground Edge Microscope Slides follow ISO 8037 glass finishing precision benchmarks ensuring safe handling and uniform thickness accuracy. Pre-Cleaned Microscope Slides comply with USP laboratory hygiene and contamination control standards ensuring ready-to-use analytical laboratory performance. Color Coated Microscope Slides meet CE laboratory consumable safety compliance ensuring chemical resistant identification surfaces. Cavity Microscope Slides comply with ISO 17025 NABL traceable dimensional accuracy validation ensuring controlled specimen containment depth. Adhesion Microscope Slides comply with ASTM optical coating durability verification ensuring long-term specimen retention stability. Hydrophilic Surface Microscope Slides follow DIN surface wetting standards ensuring enhanced biological sample spreading efficiency. Laboratory Teaching Microscope Slides comply with EN laboratory sanitation and hygiene safety compliance ensuring academic institutional usability. Each microscope slide batch undergoes optical clarity inspection, thickness tolerance validation, and chemical resistance testing prior to global export certification.
Educational Lab Equipment provides customized glass blowing and slide finishing services tailored for pharmaceutical research institutions and advanced academic laboratories requiring specification-driven glass solutions. The company ensures palletized shipping infrastructure designed for fragile laboratory glassware supported by multi-layer breakage-proof packaging guaranteeing safe long-distance international freight transport. Dedicated export logistics enable consolidated shipments combining microscope slides with laboratory glassware infrastructure for turnkey laboratory supply programs. Educational Lab Equipment supports institutional buyers through structured export compliance documentation, ensuring streamlined global procurement and secure delivery reliability. Through high-precision glass manufacturing, strict regulatory compliance, and fragile goods export expertise, Educational Lab Equipment remains a reliable international partner for microscope slide laboratory consumables.
Artery, Vein & Nerve (400x)
Product Code : EL-MS-10945
Arteries are muscular blood vessels that carry blood away from the heart. A vein is a blood vessel that carries blood toward the heart.
Note:
View Details
Smooth Muscle (400x)
Product Code : EL-MS-10946
found within the walls of hollow organs and in areas such as the bladder, uterus, abdominal cavity, GI tract, respiratory tract and iris of the eye.
Note:
View Details
Skin and Hair Follicles (40x)
Product Code : EL-MS-10947
A hair follicle is part of the skin that grows hair by packing old cells together.
Note:
View Details.jpg)
Mouth Smear (400x)
Product Code : EL-MS-10948
Human cheek cells divide about every 24 hours and are constantly shed from the body.
Note:
View Details.jpg)
Escherichia Coli (400x)
Product Code : EL-MS-10949
coli assists in waste processing, vitamin K production and food absorption. E. coli causes illness in humans.
Note:
View Details.jpg)
Chromosomes (400x)
Product Code : EL-MS-10950
A chromosome is a single long molecule of DNA, and is how DNA is organized in cells.
Note:
View Details.jpg)
Streptococcus (1000x)
Product Code : EL-MS-10951
Streptococcus is a genus of spherical gram-positive bacteria and the lactic acid bacteria group.
Note:
View Details.jpg)
Bacteria (1000x, gram stain)
Product Code : EL-MS-10952
here are about 10 times as many bacterial cells as human cells in the human body, large numbers are found on the skin and in the digestive tract.
Note:
View Details